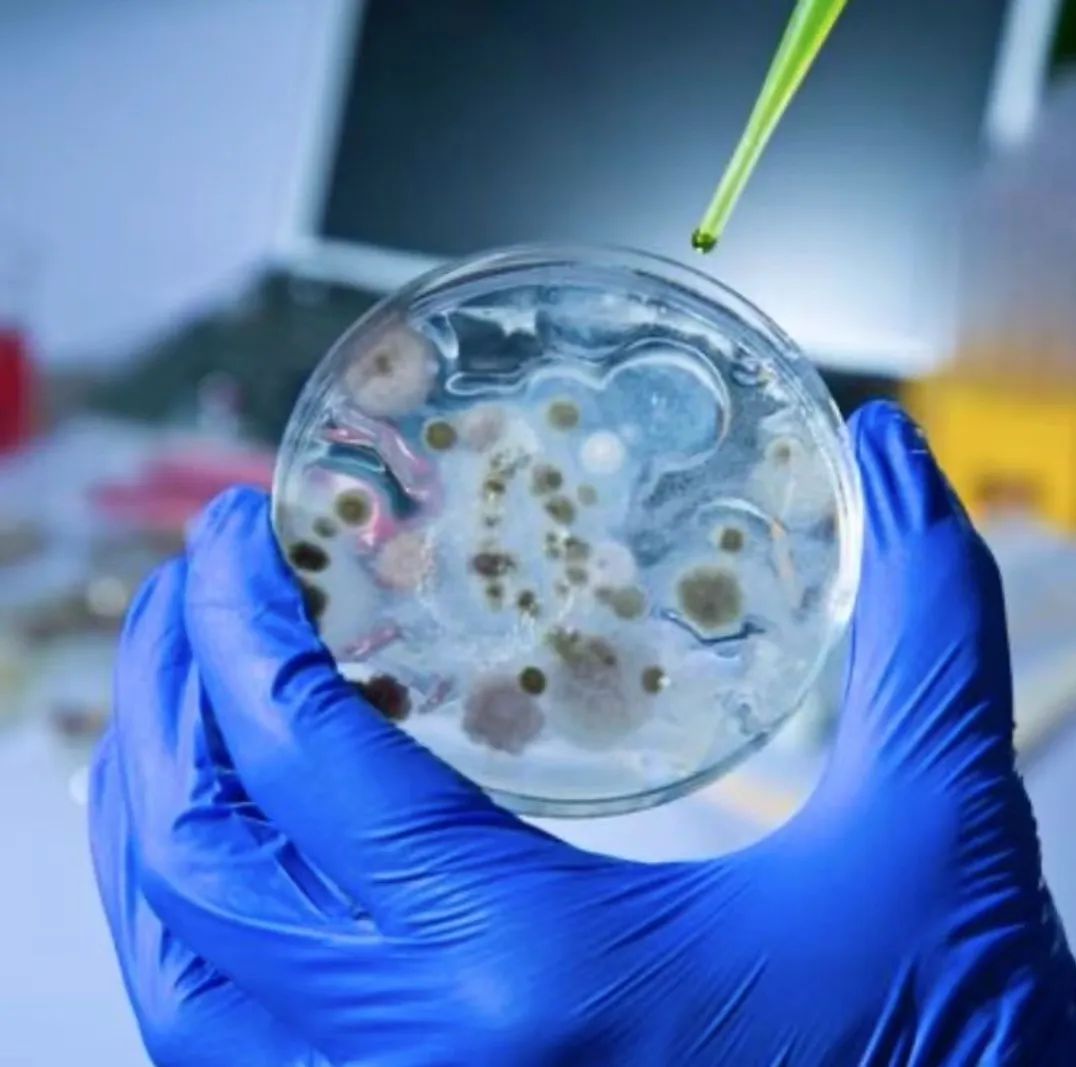

肉类泛绿光?这跟会发光的萤火虫是一回事吗?
如果您发现买回来的熟牛肉“冒绿光”,但闻起来也没有什么异味,第一反应会是什么?遇到这种情况,不少人第一反应就是:“这些肉都变质了吗?”“要不要全部扔掉?”除了熟牛肉之外,猪肉、羊肉、驴肉、鸡肉等煮熟的肉类也都会产生类似的情况。那么,这些熟肉为什么会产生绿光?会发光的肉还能吃吗?
肉类为什么会“冒绿光”?
我们先拿牛肉举个例子,如果您发现买回来的熟牛肉会发光,但闻起来也没有什么异味,这时换个角度,对着光观察这片牛肉,之前发出的绿光不见了,那完全可以放心吃下这块肉。这可能是一种光学现象,也被称为光栅衍射效应。
生活中大家也经常可以见到这种光衍射现象,比如物理课本上的三棱镜、以前十分常见的DVD光盘,以及鸟类羽毛的彩色反光、昆虫的彩色翅膀等等。
 其实,不止是切牛肉的时候会冒出绿光,饭店里拉面牛肉片的表面或卤牛肉表面,也经常会出现绿光。因为肉类并不是一种单一的物质,而是由多种蛋白质、脂肪和矿物质组成,它们都具有各自独特的化学性质,呈现不同的颜色。肉被切成很多块之后,其中的肌肉纤维也被切断,形成了规则的凹凸结构,当光照射到肉上时,会被反射、分裂或折射,也就形成了光栅效应。
其实,不止是切牛肉的时候会冒出绿光,饭店里拉面牛肉片的表面或卤牛肉表面,也经常会出现绿光。因为肉类并不是一种单一的物质,而是由多种蛋白质、脂肪和矿物质组成,它们都具有各自独特的化学性质,呈现不同的颜色。肉被切成很多块之后,其中的肌肉纤维也被切断,形成了规则的凹凸结构,当光照射到肉上时,会被反射、分裂或折射,也就形成了光栅效应。除了牛肉之外,猪肉、羊肉、驴肉、鸡肉等肉类都会产生类似的光学反应。不过,这种物理反应通常只会出现在煮熟的肉上,生肉不会出现。
 那么,为什么产生的是绿光呢?
那么,为什么产生的是绿光呢?是因为像牛肉这类红肉的肌肉纤维,含有大量的含铁化合物,所以生肉会呈现红色。在煮熟后,由于缺少含铁化合物的折射作用,红色光波会被散射或吸收,因此会产生令人不安的彩虹色或绿色。
 什么是发光细菌?
什么是发光细菌?其实肉类“冒绿光”的这种情况,实则是一种“光致发光”的物理现象,意思是说,我们之所以能看到肉类发光,需要依赖外界光源的照射。
 实际上,大自然中还有很多奇特的生物发光现象是通过化学方式形成的。像是海里的“毒手”僧帽水母、深海活化石幽灵蛸,还有奇特的小飞象章鱼,再到陆地上的萤火虫和各种发光蘑菇……
实际上,大自然中还有很多奇特的生物发光现象是通过化学方式形成的。像是海里的“毒手”僧帽水母、深海活化石幽灵蛸,还有奇特的小飞象章鱼,再到陆地上的萤火虫和各种发光蘑菇…… 再如前阵子,浙江大妈在家发现红烧海鱼半夜泛绿光这事,其实也没网友传得那么玄乎。大妈买回家红烧的是一种很常见的海洋经济鱼类“白姑鱼”,它能发光是因为感染了一种海生的发光细菌,这种细菌与海里发光的浮游生物同是引起海面发光的原因之一。
再如前阵子,浙江大妈在家发现红烧海鱼半夜泛绿光这事,其实也没网友传得那么玄乎。大妈买回家红烧的是一种很常见的海洋经济鱼类“白姑鱼”,它能发光是因为感染了一种海生的发光细菌,这种细菌与海里发光的浮游生物同是引起海面发光的原因之一。著名的“蓝眼泪”现象就是由一种叫做“希氏弯喉海萤”的浮游生物所发出的光亮形成的。这种荧光动物被海浪拍打受到刺激时,会把体内直径只有万分之一厘米的荧光素黄色颗粒和直径只有万分之二厘米的无色荧光酶颗粒与黏液一起排入水中,从而通过化学反应产生浅蓝色的光,每年夏天都吸引着大量“追泪大军”前去打卡。
 到底什么是发光细菌呢?
到底什么是发光细菌呢?其实它的发光原理和“蓝眼泪”一样,都是通过体内荧光素和荧光酶的化学反应释放光能。世界上已被发现的发光细菌多达一百几十种,也有能在猪肉的瘦肉部分存活下来的磷光发光杆菌,曾经的“荧光猪肉”事件也一度引起消费者的广泛关注。
值得庆幸的是,发光细菌并不致命。像是刚刚提到的磷光发光杆菌在自然界广泛存在,它自身的发光蛋白本身没有毒性,我国已经公布的动物传染病一、二、三类名目中均未列入此类发光杆菌。目前,我国也尚未发现有关发光杆菌对人体造成危害。并且,发光细菌不耐高温,与食材一起煮熟后是无法存活的。所以我们猜测,半夜在家里泛出绿光的海鱼估计是煮熟后没注意保存,又间接感染了发光细菌。
 当然,如果在生活中碰到会发光的肉类,建议大家还是不要食用了。因为食材发光现象还存在其他可能性,如在肉类加工或流通环节中混入了磷等其他化学发光物。
当然,如果在生活中碰到会发光的肉类,建议大家还是不要食用了。因为食材发光现象还存在其他可能性,如在肉类加工或流通环节中混入了磷等其他化学发光物。发光细菌在生活中应用在何处?
其实,科学家已经将其作为一种生物发光技术广泛应用于环境监测、农业生产、生物医学等领域。比如说,针对水污染的监测,以水蚤、藻类或鱼类为受试对象的传统生物监测法,实验周期长、过程繁琐。直到20世纪70年代,国外科学家首次从海鱼体表分离筛选出对人体无害、对环境敏感的发光细菌。简单来说,环境越好光越亮,环境越差光越被抑制。这种一目了然的生物验毒手段很快被用于监测水体生物环境。
后来,我国引进了这项技术,并先后分离出海水型和淡水型的发光细菌,用以监测不同环境污染物的生物毒性。令人骄傲的是,中国科研人员于1985年从青海湖采样获得“青海弧菌”,五年后它被确定为一种新的淡水型发光菌,并成为全世界唯一由中国学者命名的发光细菌新种。
直到今天,科学家们仍在培育一种“生物发光树”,未来它也许会成为天然的路灯,而无需电能供给。无论这种如同阿凡达般的神奇存在能否实现,都让我们看到了这项技术的无限可能!
直到今天,科学家们仍在培育一种“生物发光树”,未来它也许会成为天然的路灯,而无需电能供给。无论这种如同阿凡达般的神奇存在能否实现,都让我们看到了这项技术的无限可能!为了确保食品安全
建议大家在处理食材时
还是要格外注意清洁卫生
避免交叉污染
图源 | 《三农未知数》截图
编导、后期 | 翟海晴
编辑 | 杨笛
主编 | 蒋琳 张玮
监审 | 钟倩
原标题:《肉类泛绿光?这跟会发光的萤火虫是一回事吗?》

